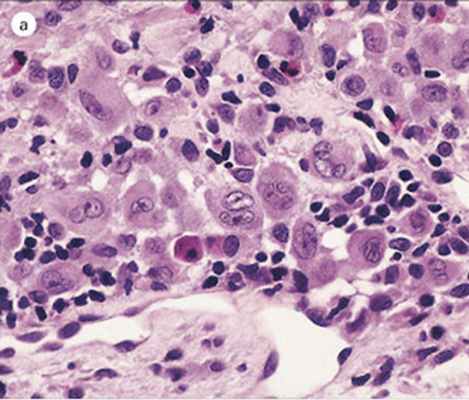
KIAI167_2022_r2.jpg
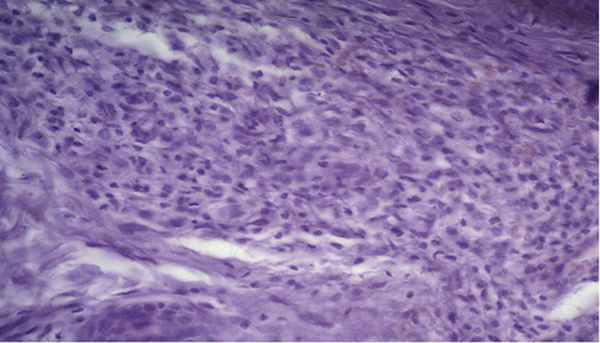
KIAI167_2022_r7.jpg

Классификация гистиоцитозов
Добавил пользователь Алексей Ф. Обновлено: 14.12.2025
Авторы: Молчанова М.В. 1 , Алексеенко С.И. 2 , Артюшкин С.А. 3
1 ФГБОУ ВО СЗГМУ им. И.И. Мечникова Минздрава России, Санкт-Петербург; СПб ГБУЗ «ДГМКЦ ВМТ им. К.А. Раухфуса», Санкт-Петербург
2 ФГБОУ ВО СЗГМУ им. И.И. Мечникова Минздрава России, Санкт-Петербург ; СПб ГБУЗ «ДГМКЦ ВМТ им. К.А. Раухфуса», Санкт-Петербург
3 ФГБОУ ВО «СЗГМУ им. И.И. Мечникова» МЗ РФ, Санкт-Петербург
Гистиоцитозы представляют собой группу заболеваний, которые объединяет пролиферативный процесс в моноцитарно-макрофагальной системе с накоплением в очагах поражения патологических гистиоцитов и формированием специфических гранулем.
Возможна иммунопатологическая и опухолевая природа заболевания. В пользу иммунопатологической природы гистиоцитоза свидетельствуют высокая частота спонтанных ремиссий, низкая летальность и отсутствие хромосомных аномалий в клетках из очагов поражения, в пользу опухолевой природы — клональный характер пролиферации клеток Лангерганса в очагах поражения.
Клинические проявления гистиоцитоза весьма разнообразны, что определяет трудность диагностики. В патологический процесс могут вовлекаться различные органы и ткани: кожа, лимфатические узлы, наружное и среднее ухо, плоские кости, костный мозг, печень, селезенка, легкие, эндокринные железы, желудочно-кишечный тракт, головной мозг.
В статье представлен клинический случай гистиоцитоза, диагностированный у ребенка 1 мес. 3 нед., клинические проявления которого маскировались под симптомы наружного диффузного отита.
Описание данного клинического случая преследует цель обратить внимание на особенности течения рецидивирующих наружных и средних отитов у грудных детей, т. к. за маской данных заболеваний может скрываться гистиоцитоз.
Ключевые слова: наружный и средний диффузный отит, дети грудного возраста, гистиоцитоз, компьютерная томография.
Для цитирования: Молчанова М.В., Алексеенко С.И., Артюшкин С.А. Клиническое наблюдение гистиоцитоза у ребенка 1 месяца 3 недель, протекавшего под маской наружного диффузного отита. РМЖ. 2018;10(II):102-104.
Clinical observation of histiocytosis, proceeding under the mask of an acute otitis externa, in a child of 1 month 3 weeks
M.V. Molchanova 1,2 , S.I. Alexeenko 1,2 , S.A. Artyushkin 1
1 Mechnikov Northwestern State Medical University, Saint Petersburg
2 Raukhfus Children City Multi-Profile Clinical Center of High Medical Technologies, Saint Petersburg
A histiocytosis is a group of diseases that combine the proliferative process in the monocyte-macrophage system with the accumulation of pathological histiocytes in the lesions and a formation of specific granulomas.
There is a possibility of an immunopathological and tumor nature of the disease. A high incidence of spontaneous remission, low mortality and an absence of chromosomal abnormalities in cells from lesions are in favor of the immunopathological nature of histiocytosis. In favor of the tumor nature — the clonal nature of the Langerhans cells proliferation in the lesions.
Clinical manifestations of histiocytosis are very diverse, which determines the difficulty of diagnosis. Various organs and tissues can be involved in the pathological process: skin, lymph nodes, external and middle ear, flat bones, bone marrow, liver, spleen, lungs, endocrine glands, gastrointestinal tract, brain.
The article presents a clinical case of histiocytosis diagnosed in a child of 1 month 3 weeks, the clinical manifestations of which were masked under the symptoms of an acute otitis externa.
The description of this clinical case is intended to draw attention to the peculiarities of the course of recurrent otitis externa and otitis media in infants, as the “mask” of these diseases may be histiocytosis.
Key words: acute otitis externa and otitis media, infants, histiocytosis, computerized tomography.
For citation: Molchanova M.V., Alexeenko S.I., Artyushkin S.A. Clinical observation of histiocytosis, proceeding under the mask of an acute otitis externa, in a child of 1 month 3 weeks // RMJ. 2018. № 10(II). P. 102–104.
В статье представлен клинический случай гистиоцитоза, диагностированный у ребенка 1 мес. 3 нед., клинические проявления которого маскировались под симптомы наружного диффузного отита.
Введение
Гистиоцитозы представляют собой группу заболеваний, разнообразных по клиническим проявлениям и прогнозу, которые объединяет пролиферативный процесс в моноцитарно-макрофагальной системе с накоплением в очагах поражения патологических гистиоцитов и формированием специфических гранулем [1–4]. Современная классификация гистиоцитозов включает 3 нозологические формы: гистиоцитоз из клеток Лангерганса, злокачественный гистиоцитоз и вирус-ассоциированный гемофагоцитарный синдром [2, 5].
Гистиоцитоз из клеток Лангерганса — крайне редкое заболевание: в детском возрасте встречаются 3–4 случая на 1 млн населения, у взрослых — 1 случай на 560 000 населения [6–8].
Этиология и патогенез гистиоцитоза до конца не изучены [2, 6, 9]. Возможна иммунопатологическая и опухолевая природа заболевания. В пользу иммунопатологической природы гистиоцитоза свидетельствуют высокая частота спонтанных ремиссий, низкая летальность (у детей — 15%, у взрослых — 3%) и отсутствие хромосомных аномалий в клетках из очагов поражения. В пользу опухолевой природы говорит клональный характер пролиферации клеток Лангерганса в очагах поражения [10].
Клинические проявления гистиоцитоза весьма разнообразны, что определяет трудность диагностики. В патологический процесс могут вовлекаться различные органы и ткани: кожа, лимфатические узлы, наружное и среднее ухо, плоские кости, костный мозг, печень, селезенка, легкие, эндокринные железы, желудочно-кишечный тракт, головной мозг [2, 6, 11].
Среди ЛОР-органов наиболее часто поражаются наружное и среднее ухо с кровянисто-гнойными выделениями из наружного слухового прохода, имитируя таким образом наружный и средний гнойный отит.
Верификация диагноза проводится на основании биопсии пораженных очагов с последующим гистологическим и иммуногистохимическим исследованиями материала [2].
Клинический случай гистиоцитоза
Вашему вниманию предлагается случай своевременно диагностированного гистиоцитоза у ребенка грудного возраста.
Девочка Г., 1 мес. 3 нед., поступила в ЛОР-отделение СПб ГБУЗ «ДГМКЦ ВМТ им. К.А. Раухфуса» в экстренном порядке с жалобами на геморрагические выделения из правого уха.
Из анамнеза заболевания известно, что за 2 нед. до поступления на фоне полного здоровья родители заметили геморрагические выделения из правого уха у девочки в небольшом количестве. Факт травмы родители отрицали. К ЛОР-врачу амбулаторно не обращались. Появившиеся выделения из правого уха повторно побудили родителей обратиться в дежурный ЛОР-стационар.
Из анамнеза жизни известно, что девочка от первой беременности, первых срочных родов. Беременность протекала без особенностей. При рождении: масса тела — 3650 г, рост — 53 см, закричала сразу, оценка по шкале Апгар — 8/8 баллов. Девочка находилась на грудном вскармливании, отмечались достаточные весовые прибавки. Проходила регулярные плановые осмотры в декретированные сроки у педиатра и специалистов в поликлинике по месту жительства. Девочка наблюдается у хирурга, онколога по месту жительства по поводу образования боковой поверхности грудной клетки слева (лимфангиома?).
При поступлении: ребенок в сознании, активен, сон не нарушен, аппетит не снижен. Температура тела 36,5 °С. Общий соматический статус без отклонений от возрастной нормы.
Проведена оценка ЛОР-статуса. Риноскопия: носовое дыхание удовлетворительное. Слизистая носа розовая, носовые раковины обычные, отделяемого нет. Фарингоскопия: слизистая глотки розовая, налетов не обнаружено.

Выполнена отоскопия. AD: заушная область не изменена. Кожа наружного слухового прохода незначительно гиперемирована, инфильтрирована. В наружном слуховом проходе отмечается гнойно-геморрагическое отделяемое. На задневерхней стенке наружного слухового прохода на границе с барабанной перепонкой визуализируется образование розового цвета, однородное, с четкими контурами, размер 7×5,5 мм, при дотрагивании кровоточит. Барабанная перепонка обозрима не полностью, серая. AS: заушная область не изменена. Наружный слуховой проход широкий, свободный. Барабанная перепонка серая, контуры четкие.
Ребенок госпитализирован в ЛОР-отделение, проведено дообследование: клинический анализ крови, общий анализ мочи, копрограмма, бактериологическое исследование патологического отделяемого из правого уха, УЗИ органов брюшной полости, желудка, биохимический анализ крови, ЭКГ, консультация педиатра.
После угасания острого воспалительного процесса наружного слухового прохода справа выполнена компьютерная томография височных костей с внутривенным введением контрастного вещества.
В клиническом анализе крови отмечались признаки анемии легкой степени тяжести (эритроциты 3,09×10 12 , гемоглобин 100 г/л).
В общем анализе мочи, копрограмме, УЗИ органов брюшной полости, желудка патологии не выявлено.
В результате бактериологического исследования отделяемого из наружного слухового прохода справа выделен Staphylococcus aureus, чувствительный к амоксициллину в комбинации с клавулановой кислотой, цефотаксиму, цефтриаксону.
ЭКГ: синусовый ритм с ЧСС 138 уд./мин, нормальное положение электрической оси сердца. Поворот против часовой стрелки (R1, V1–V6); неполная блокада правой ножки пучка Гиса.
Девочка консультирована педиатром. Диагноз: Образование боковой поверхности грудной клетки слева (лимфангиома?). Анемия легкой степени тяжести.
Проведена консервативная терапия: системная антибактериальная терапия (цефтриаксон по 400 мг 1 р./сут в/м 10 дней); антигистаминная терапия (диметинден (капли) по 3 капли 3 р./сут внутрь); интраназально вводился вазоконстриктор (оксиметазолин 0,01% по 1 капле 2 р./сут); местный антибактериальный препарат (в правое ухо: рифамицин по 3 капли 3 р./сут 10 дней).
На фоне проводимой терапии воспалительные явления стихли, однако при отоскопии сохранялось образование на задневерхней стенке наружного слухового прохода справа.
С целью уточнения распространенности процесса назначена компьютерная томография височных костей с внутривенным введением контрастного вещества.
По данным компьютерной томографии височных костей, выполненной по стандартной программе до и после внутривенного введения контрастного вещества, на задней стенке наружного слухового прохода справа определяется мягкотканное образование однородной структуры, овальной формы с четкими контурами, размером 7×5,5 мм. Образование прилежит к барабанной перепонке, несколько смещает ее внутрь, умеренно накапливает контрастный препарат. Просвет наружного слухового прохода в данной области сужен до 1 мм. Костных деструктивных изменений не выявлено. Антрум и барабанные полости с обеих сторон пневматизированы. Слуховые косточки прослеживаются четко. Улитки без особенностей (рис. 1).
В условиях операционной под внутривенным наркозом при отомикроскопическом контроле удалено образование наружного слухового прохода справа. Материал направлен на гистологическое исследование.
По результатам патоморфологического исследования: гистологическая картина лангергансоклеточного гистиоцитоза.
Девочка консультирована детским онкологом. Рекомендован пересмотр блоков и стекол с выполнением иммуногистохимического исследования материала в НМИЦ ДГОИ им. Д. Рогачева.
Катамнез: по результатам гистологического и иммуногистохимического исследования в НМИЦ ДГОИ им. Д. Рогачева диагноз подтвержден. После выписки из ЛОР-отделения ДГМКЦ ВМТ им. К.А. Раухфуса девочка прошла обследование у онколога, другие очаги не выявлены. Системная терапия онкологом не назначалась. В течение года 1 раз в 3 мес. консультируется онкологом, оториноларингологом, ребенку проводится отомикроскопия — отмечается стойкая ремиссия.
Заключение
Описание данного клинического случая преследует цель обратить внимание на особенности течения рецидивирующих наружных и средних отитов у грудных детей, т. к. за маской данных заболеваний может скрываться гистиоцитоз.
Контент доступен под лицензией Creative Commons «Attribution» («Атрибуция») 4.0 Всемирная.
Подходы к диагностике лангергансоклеточного гистиоцитоза
Гистиоцитоз – группа редких заболеваний, считающихся реактивными, но с широким спектром степени тяжести. Согласно классификации гистиоцитоза, разработанной Обществом гистиоцитоза, различают лангергансоклеточный гистиоцитоз (ЛКГ), нелангергансоклеточный гистиоцитоз (НЛКГ) и злокачественный гистиоцитоз [7].
Классификация гистиоцитоза, разработанная Обществом гистиоцитоза
- Класс I: лангергансоклеточный гистиоцитоз.
- Класс II: гистиоцитоз системы мононуклеаров-фагоцитов, или нелангергансоклеточный гистиоцитоз:
- IIa: гистиоцитоз, поражающий дермальные дендроциты, положительные на CD68 и фактор XIII (гистиоцитоз, поражающий клетки дермальной дендроцитной линии);
- IIb: гистиоцитоз, поражающий клетки, отличные от клеток Лангерганса и клеток дермальной дендроцитной линии.
ЛКГ – заболевание с широким спектром форм: локализованной, асимптомной с вялым течением, ограниченной изолированным поражением костей или системной и агрессивной, с вовлечением множества органов и выраженными симптомами. Патогенез ЛКГ остается неизвестным, обсуждается реактивная и неопластическая природа заболевания. Самой вероятной гипотезой является клональное происхождение клеток ЛКГ у генетически предрасположенных пациентов [3, 6].
Клинический спектр ЛКГ:
- болезнь Леттера–Сайва – острая, диссеминированная, мультисистемная форма, которая обычно возникает у грудных детей и новорожденных и без лечения заканчивается летально;
- болезнь Ханд–Шюллера–Кристиана (БХШК) – хроническая прогрессирующая мультифокальная форма, начинающаяся в детском возрасте;
- эозинофильная гранулема (ЭГ) является локализованной, доброкачественной формой, течение вялое, поражаются кожа и/или кости;
- болезнь Хашимото–Притцкера (БХП) – самоизлечивающийся вариант ЛКГ, обычно возникающий при рождении или в первые дни жизни.
Обществом гистиоцитоза были предложены следующие диагностические критерии гистиоцитоза класса І:
1) предварительный диагноз – морфологические признаки;
2) вероятный диагноз – морфологические признаки + два или более дополнительных положительных результата при окрашивании на аденозин трифосфатазу, белок S100, альфа-D-маннозидазу или арахисовый лецитин;
3) установленный диагноз – морфологические признаки + гранулы Бирбека в пораженных клетках, видимые при электронной микроскопии, и/или положительные результаты окрашивания на CD1a [3, 6].
Кожные проявления при ЛКГ наблюдаются часто и могут служить ранними признаками заболевания. Типичным поражением является небольшая прозрачная папула, 1–2 мм в диаметре, розово-желтого цвета, обычно локализуется на туловище и коже волосистой части головы, часто сопровождается шелушением; при папулонодулярных поражениях могут возникать изъязвления, которые покрываются коркой. Могут возникать везикулы и пустулы, что заставляет проводить дифференциальную диагностику с экземой, чесоткой и ветрянкой. Это самые частые симптомы неонатального периода (первый месяц жизни). Наличие пурпуры является плохим прогностическим признаком [2, 4].
Очаги поражения кожи покрываются коркой более или менее быстро и имеют склонность к слиянию на волосистой части головы, что напоминает себорейный дерматит или фолликулит, ведущий к алопеции, а также в складках кожи (заушной, подмышечной, генитальных), что напоминает интертриго. Иногда очаги сливаются в бляшки на передней поверхности грудной клетки, спине, височно-теменных областях и становятся ксантоматозными [4, 6].
Очаги поражения слизистых оболочек часто изъязвляются и располагаются в основном вокруг ротового отверстия, на деснах и, особенно при ЭГ, в области гениталий и ануса. Хотя отсутствие поражений слизистой оболочки является ключевым признаком БХП, проявления на слизистых могут быть первым признаком ЛКГ: могут наблюдаться неспецифическая боль, афты, кровотечения из десен, кандидоз, изъязвления с потерей зубов и преждевременное прорезывание зубов [4, 8].
Изменения ногтей включают их хрупкость, паронихию, подногтевой гиперкератоз, продольные борозды и пигментированные и пурпурные стрии ногтевого ложа. Эти симптомы считаются неблагоприятными прогностическими признаками [6].
Сопутствующие клинические симптомы
Часто при агрессивных формах отмечаются недомогание, потеря массы тела, задержка развития, тошнота, миалгия, артралгия и лихорадка. Поражения костей (80% случаев) являются самыми частыми проявлениями ЛКГ, моносимптомное поражение костей наблюдается в 50–60% случаев. Поражения чаще возникают на коже головы, особенно в височно-теменной области, где инфильтраты ведут к образованию ограниченных очагов остеолиза, которые сливаются с образованием типичных поражений в виде «географической карты». Поражение костей глазницы приводит к экзофтальму.
Кроме того, могут поражаться плоские кости, позвонки и длинные кости. Остеолитические поражения, как асимптомные, так и сопровождающиеся болью, обычно множественные и распространенные. Распространение на окружающие ткани (например, мышцы) может вызвать симптомы, не связанные с поражением костей. Поражения могут развиваться незаметно, и патологические изменения костей могут не диагностироваться до спонтанного перелома. В диагностике поражения костей при ЛКГ можно использовать как обычную рентгенографию, так и КТ и МРТ [3, 6].
Поражения легких у пациентов пожилого возраста могут быть бессимптомными и встречаются довольно часто (12–23% случаев). Функциональные симптомы включают диспноэ, тахипноэ с ретракцией ребер, кашель, цианоз и боль в грудной клетке. Диагноз ЛКГ устанавливается при наличии более 5% клеток Лангерганса в образцах, полученных из бронхоальвеолярного лаважа, обнаруженных при иммунологическом окрашивании или исследовании под электронным микроскопом.
Поражения печени и селезенки наблюдаются достаточно часто (15–50% пациентов). Поражения печени могут включать тяжелый фиброз, билиарный цирроз и печеночную недостаточность. Гепатоспленомегалия, часто вследствие портальной инфильтрации клетками Лангерганса или гиперплазии клеток Купфера, никогда не является начальным признаком заболевания, но является частым осложнением и прогностически неблагоприятным симптомом. Тромбоцитопения может отягощаться спленомегалией.
Лимфаденопатия редко является выраженной, но отмечается в 25–75% летальных случаев. Чаще поражаются шейные лимфатические узлы, их увеличение лишь изредка проявляется симптомами, но при массивном процессе может приводить к компрессии сосудов и органов. Может наблюдаться нагноение и формирование свищей.
Несахарный диабет наблюдается более чем в 50% случаев и чаще всего выявляется у пациентов с поражением черепа и глазниц. Хотя несахарный диабет является очевидным маркером распространения процесса в полость черепа, он не считается прогностически неблагоприятным симптомом.
Экзофтальм отмечается только в 10–30% случаев. Он может быть односторонним или двухсторонним и быть вызван инфильтрацией позадиглазничной кости клетками Лангерганса.
Желудочно-кишечные симптомы неспецифичны и обусловлены инфильтрацией слизистой оболочки. Диагноз может быть установлен только по данным эндоскопии и биопсии.
Гистопатологические признаки
Патологические признаки ЛКГ отмечаются при любой форме заболевания (рис. 1). Общим элементом различных поражений является типичная «клетка ЛКГ» (рис. 2, 3), хорошо различимая и отличающаяся от неспецифических элементов инфильтрата размером и формой. Эта клетка в размере в 4–5 раз превосходит мелкие лимфоциты, имеет неправильное и пузырчатое ядро, часто почковидное, и слегка эозинофильную цитоплазму.
![KIAI167_2022_r1-300x256.jpg]()
Рис. 1. ЛКГ. Очаговый плотный полиморфный инфильтрат с сильной эпидермотропностью, локализующийся периваскулярно и перифолликулярно
![KIAI167_2022_r1.jpg]()
Рис. 1. ЛКГ. Очаговый плотный полиморфный инфильтрат с сильной эпидермотропностью, локализующийся периваскулярно и перифолликулярно
![KIAI167_2022_r2-300x256.jpg]()
Рис. 2. ЛКГ. Типичная клетка ЛКГ – гистиоцит с неравномерно пузырчатым, часто почковидным ядром и обильной, слегка эозинофильной цитоплазмой
![KIAI167_2022_r2.jpg]()
Рис. 2. ЛКГ. Типичная клетка ЛКГ – гистиоцит с неравномерно пузырчатым, часто почковидным ядром и обильной, слегка эозинофильной цитоплазмой
![KIAI167_2022_r3-300x256.jpg]()
Рис. 3. ЛКГ. Различают следующие группы пролиферирующих клеток: атипичные неопластические гистиоциты; макрофаги с ядрами различной конфигурации; хорошо дифференцированные гистиоциты
![KIAI167_2022_r3.jpg]()
Рис. 3. ЛКГ. Различают следующие группы пролиферирующих клеток: атипичные неопластические гистиоциты; макрофаги с ядрами различной конфигурации; хорошо дифференцированные гистиоциты
Гистологические признаки, наблюдаемые при ЛКГ, делятся на три типа: пролиферативные, гранулематозные и ксантоматозные. В ранних папулах наблюдается пролиферативная реакция. Она состоит из обширной эпидермотропной, лихеноидной инфильтрации клетками ЛКГ в верхнем слое дермы. Эпидермис в скором времени сдавливается, истончается и может даже разрушаться. Гранулематозная реакция включает присутствие в инфильтрате многоядерных гистиоцитов, различного количества эозинофилов, а также нейтрофилов, лимфоцитов и плазматических клеток. Этот тип реакции наблюдается при хроническом течении заболевания. Ксантоматозная реакция встречается в основном при БХШК и включает многочисленные пенистые клетки, перемешанные с клетками ЛКГ и эозинофилами. Часто наблюдаются многоядерные гигантские клетки, которые могут иметь вид гигантских клеток Тутона [1, 5].
![KIAI167_2022_r4-300x256.jpg]()
Рис. 4. Ультраструктурно в гистиоцитах выявляются специфические образования в виде «ракеток», которые служат надежным диагностическим маркером гистиоцитоза Х
![KIAI167_2022_r4.jpg]()
Рис. 4. Ультраструктурно в гистиоцитах выявляются специфические образования в виде «ракеток», которые служат надежным диагностическим маркером гистиоцитоза Х
Клетки ЛКГ имеют иммунофенотип нормальных клеток Лангерганса, экспрессируя высокие уровни молекул большого комплекса гистосовместимости ІІ, комплекса CD1, CD4, молекул CD207 и белка S100. Электронная микроскопия показала, что примерно 50% гистиоцитов ЛКГ содержат гранулы Лангерганса (рис. 4) [1, 5, 6].
Собственное наблюдение
Пациент Д., 47 лет, обратился на кафедру дерматовенерологии с жалобами на высыпания на коже туловища и конечностей, сопровождающиеся незначительным зудом.
Считает себя больным в течение нескольких лет, с тех пор как впервые появились высыпания на коже. Кроме того, высыпания сопровождались лимфаденопатией. Пациенту были назначены дополнительные обследования, в том числе биопсия лимфатического узла. Несмотря на проведенные обследования, точный диагноз установлен не был, что заставило пациента обратиться на кафедру для проведения диагностической биопсии.
![KIAI167_2022_r5-300x256.jpg]()
Рис. 5. Пациент Д., 47 лет. Диагноз: ЛКГ (здесь и далее – фото предоставлены автором)
![KIAI167_2022_r5.jpg]()
Рис. 5. Пациент Д., 47 лет. Диагноз: ЛКГ (здесь и далее – фото предоставлены автором)
При осмотре: патологический процесс на коже носит распространенный, симметричный, хронический характер. Высыпания расположены на коже разгибательных и сгибательных поверхностей верхних и нижних конечностей, туловища и представлены сливными папулами с образованием сплошных инфильтрированных очагов яркого-красного цвета с желтоватым оттенком (рис. 5).
Для установления окончательного диагноза пациенту было рекомендовано патогистологическое исследование кожи.
Результаты патогистологического исследования: очаговый плотный полиморфный инфильтрат с выраженной эпидермотропностью, локализующийся периваскулярно и перифолликулярно; инфильтрат представлен атипичными гистиоцитами с примесью эозинофилов, нейтрофилов и лимфоцитов (рис. 6, 7).
![KIAI167_2022_r6-300x256.jpg]()
Рис. 6. Гистологический препарат пациента с ЛКГ (окраска гематоксилин-эозин)
![KIAI167_2022_r6.jpg]()
Рис. 6. Гистологический препарат пациента с ЛКГ (окраска гематоксилин-эозин)
Рис. 7. Гистологический препарат пациента с ЛКГ (окраска гематоксилин-эозин). Полиморфноклеточный инфильтрат состоит из атипичных гистиоцитов, нейтрофилов, эозинофилов, плазмоцитов и лимфоцитов
![KIAI167_2022_r7.jpg]()
Рис. 7. Гистологический препарат пациента с ЛКГ (окраска гематоксилин-эозин). Полиморфноклеточный инфильтрат состоит из атипичных гистиоцитов, нейтрофилов, эозинофилов, плазмоцитов и лимфоцитов
Кроме того, было проведено повторное исследование биоптата лимфатического узла, где также обнаружили полиморфный инфильтрат, представленный атипичными гистиоцитами, нейтрофилами, эозинофилами, лимфоцитами и плазмоцитами. Дополнительно было проведено иммуногистохимическое исследование биоптатов кожи и лимфатического узла.
При иммуногистохимическом исследовании выявлена экспрессия CD4, S100, CD1a, CD207, CD68, что позволило установить диагноз ЛКГ.
Пациент был направлен в Институт рака для последующего лечения и диспансерного наблюдения.
Таким образом, сложности диагностики такого редко встречающегося в дерматологической практике заболевания, как ЛКГ кожи, требует анализа данных клинической картины, обязательного гистологического исследования не только биоптатов кожи, но и других органов, которые вовлечены в патологический процесс, где наблюдаются сходные патогистологические изменения. Совокупность всех данных позволяет установить диагноз и назначить пациенту соответствующее и своевременное лечение.
Классификация гистиоцитозов
Гистиоцитозы - классификация, диагностика, лечение
Гистиоцитозы - группа опухолевых заболеваний составляет 3-4% от всех опухолей детского возраста. Опухоли развиваются из макрофагально/моноцитарной группы клеток.
Эти клетки образуются в костном мозге, некоторое время циркулируют в крови в виде моноцитов, а затем мигрируют в ткани, где образуют макрофагальные элементы печени, селезенки, легких, костного мозга и тканей (гистиоциты) или антиген-продуцирующие клетки (дендритные клетки).
Заболевания, относящиеся к 1 классу, часто многоочагового характера, проявляют чувствительность к цитостатикам и излучению и могут приводить к смертельному исходу.
Классификация гистиоцитозов недавно была пересмотрена, и сейчас она основывается на характеристике инфильтрирующих гистиоцитов.
1. Гистиоцитозы 1 класса характеризуются присутствием клеток Лангерганса. Эти клетки могут быть незлокачественными и способны реагировать на медиаторы иммунного ответа. В электронном микроскопе в них можно видеть типичные гранулы Бирбека. Пока нет единого мнения по поводу того, является ли это заболевание злокачественным. Однако в некоторых исследованиях продемонстрирована моноклональная природа этих клеток.
2. Гистиоцитозы класса 2 характеризуются наличием инфильтратов реактивных макрофагов. К этому классу относятся два редких вида заболевания, которые быстро заканчиваются смертельным исходом, семейный эритрофагоцитарный лимфогистиоцитоз и инфекционный гемофагоцитарный синдром.
3. К классу 3 относятся злокачественные опухоли гистиоцитарного происхождения, включая моноцитарный лейкоз.![Варианты гистиоцитоза Х]()
Гистиоцитоз из клеток Лангерганса (1 класс гистиоцитозов)
Гистиоцитоз из клеток Лангерганса (ГКЛ) обычно называют гистиоцитозом X. Он объединяет целый ряд заболеваний: болезнь Леттерера-Сиве эозинофильную гранулему и болезнь Хенда-Шюллера-Кристиана. Болезнь Леттерера-Сиве представляет собой острое заболевание детского возраста, характеризующееся гепатоспленомегалией, набуханием лимфатических узлов, тромбоцитопенией и развитием кожной сыпи.
При обследовании обычно обнаруживаются себор-рейные высыпания на волосистой части головы, имеющие вид чешуйчатых напластований Образование многочисленных инфильтратов в коже, печени, селезенке и в костном мозге приводит к фунциональным расстройствам печени, одышке и к нарушениям функции костного мозга. Часто в костях развиваются литические очаги. Болезнь, ранее известная под названием эозинофильная гранулема, характеризуется рядом синдромов: от отдельных повреждений, развивающихся на костях, обычно у старших детей, до множественных проникающих костных повреждений.
Для детей моложе 3 лет прогноз оказывается неблагоприятным. Обычно детей беспокоят боли в костях, при осмотре обнаруживается лимфоаденопатия. Известны случаи спонтанного излечения. У некоторых детей обнаруживаются множественные эозинофильные гранулемы.
Иногда диагносцируется несахарный диабет, который развивается на почве поражения гипофиза или вызывается опухолью локализованной в глазнице (болезнь Хенда-Шюллера-Кристиана). Также наблюдается увеличение размеров печени и селезенки и появление кожных инфильтратов, однако эта болезнь носит менее агрессивный характер, чем болезнь Леттерера-Сиве. Как при эозинофильной гранулеме, развитие болезни может прекратиться, и по прошествии 3-4 лет рецидивы больше не наблюдаются.
Несахарный диабет принимает хроническую форму. Может развиться такое хроническое неврологическое расстройство как печеночная энцефалопатия на фоне цирроза с портальной гипертензией.
Прогноз и лечение гистиоцитозов у детей
Максимальная смертность наблюдается у маленьких детей и при инфильтрации опухолью внутренних органов (легких, печени и костного мозга). Отдельные повреждения костей лечат выскабливанием и местным назначением стероидов. Нередко эффективной оказывается лучевая терапия, назначенная в небольших дозах, однако при этом увеличивается риск развития костных сарком в отдаленные сроки после облучения. Больных с более распространенным опухолевым процессом можно лечить цитостатиками.
Наиболее часто назначают преднизолон, винбластин, этопозид, хлорамбуцил и метотрексат. Однако болезнь может протекать очень вяло и проходить даже без лечения, поэтому крайне важно избегать развития токсикозов. Во многих случаях (особенно когда болезнь ограничена поражением костей) лечение можно приостановить на длительный срок.
Редактор: Искандер Милевски. Дата обновления публикации: 18.3.2021
Гистиоцитоз
Гистиоцитоз — это клональное пролиферативное заболевание, при котором происходит активное размножение патологических иммунных клеток гистиоцитов и эозинофилов, которые инфильтрируют органы, вызывая в них фиброзные изменения и, как следствие, нарушение их работы.
Причины развития гистиоцитоза
Причины развития гистиоцитоза остаются предметом исследований. Наследственная теория не нашла своего подтверждения. Предполагается, что сбой в работе иммунной системы и развитие аутоагрессии может быть спровоцировано вирусом герпеса 6 типа. Также есть данные о том, что развитие болезни может быть спровоцировано курением табака. Об этом свидетельствует тот факт, что около 90% взрослых больных являются курильщиками, а отказ от курения уменьшает симптомы гистиоцитоза даже без применения терапии. У 50% больных гистиоцитозом в клетках Лангерганса обнаруживается мутация V600E в гене, который кодирует белок BRAF.
Патогенез заболевания также до конца не изучен. Основным звеном считается накопление в тканях патологически измененных дендритных клеток. В норме они синтезируются в костном мозге и оттуда мигрируют в некоторые органы. Там они занимаются поглощением чужеродных агентов (антигенов), которые поступают в организм из внешней среды, а также «обучением» лимфоцитов для формирования иммунного ответа.
При гистиоцитозе в гистиоцитах нарушается процесс запрограммированной гибели (апоптоз). В свою очередь, медиаторы воспаления, которые синтезируются лимфоцитами, стимулируют рост и интенсивную пролиферацию гистиоцитов, что приводит к их активному размножению и слиянию с эозинофилами. Итогом является образование гигантоклеточных гранулем, которые замещают нормальную ткань органов и приводят к нарушению его работы.
Классификация гистиоцитоза
В зависимости от локализации очагов поражения выделяют:
- Гистиоцитоз с единичным поражением одной анатомической области. Например, может иметься единичный очаг в коже, кости, легком или лимфатическом узле.
- Множественная форма с поражением одной анатомической области — в одном органе может быть несколько очагов поражения.
- С вовлечением 2 и более органов, но без нарушения их функции.
- С вовлечением нескольких органов с нарушением их функции.
Симптомы гистиоцитоза
В клиническом течении выделяют 2 вида заболевания: моносистемный и мультисистемный. При моносистемном варианте страдает один орган, во втором случае — 2 и более.
Моносистемный гистиоцитоз
Наиболее часто при моносистемном гистиоцитозе отмечается поражение костей. В первую очередь, страдают кости черепа, реже гранулемы локализуются в трубчатых костях, костях таза и позвонках. Нередки случаи, когда болезнь протекает бессимптомно, но бывают и клинические проявления, например, болезненная отечность в зоне поражения, изъязвления кожи. Поражение костей может спонтанно регрессировать или трансформироваться в системный процесс.
Второе место после поражения костей при моносистемной форме гистиоцитоза занимает кожа. Проявления имеют вид узловых образований, множественных папул или язвенных бляшек. Локализуются они чаще в генитальной и перианальной области. Может отмечаться и экстрагенитальная локализация, например, на лице, туловище или руках.
Поражение легких. Это проявление чаще встречается у взрослых людей. Симптомами служат сухой кашель, боли в грудной клетки, ночная потливость, повышение температуры. Может отмечаться снижение массы тела.
Мультисистемный гистиоцитоз может развиваться в любом возрасте, но чаще страдают дети. Наиболее сложная форма заболевания (диссеминированный гистиоцитоз) приходится на первые 2-6 лет жизни человека.
Болезнь Леттера-Сиве. Начинается с повышения температуры и/или сыпи на коже. Чуть реже начало характеризуется поражением внутренних органов. Кожные проявления очень вариабельны и диссеминированы. На голове, груди и между лопаток располагаются жирные корки, напоминающие себорею. На коже туловища и в паховых складках образуются обильные папулы коричневого, красного или желтого цветов, в их центре могут быть пузырьки.
В дальнейшем возможно мокнутие, изъязвление и даже некротизация. Симптомы поражения внутренних органов вариабельны, от бессимптомного течения, до грубой патологии. При поражении костного мозга отмечается анемия, тромбоцитопения, которая может привести к геморрагической сыпи. Костные и легочные проявления аналогичны моносистемному варианту гистиоцитоза.
Болезнь Хенда-Шюллера-Крисчена — это еще один вариант гистиоцитоза. Развивается в основном у детей. Характеризуется классической триадой: поражение костей, экзофтальм и несахарный диабет. Также могут иметься характерные для гистиоцитоза поражения кожи и внутренних органов. Экзофтальм (выпячивание глаза) развивается вследствие образования гранулем в области мягких тканей глаза или глазницы. Диабет образуется в следствие гипофизарно-питуитарного поражения. На этом фоне могут быть неврологические нарушения, которые обусловлены как поражением головного мозга, так и костей черепа.
При мультифокальных формах гистиоцитоза в процесс могут вовлекаться следующие органы:
- Лимфатические узлы — проявляется лимфаденопатией (увеличением лимфатических узлов), в ряде случаев лимфоузлы могут сливаться и образовывать конгломераты.
- Ухо. Характерны наружные отиты, которые плохо реагируют на антибиотики.
- Печень. Поражения печени проявляются гепатомегалией, желтухой, а также симптомами, которые свидетельствуют о тяжелой печеночной недостаточности (отеки, кровотечения, энцефалопатии).
- Селезенка. Проявляется спленомегалией.
- Костный мозг. Поражение костного мозга ведет к угнетению кроветворения и, как следствие, развитию пенических синдромов, например, анемии, тромбоцитопении с повышенной кровоточивостью, нейтропении и развитием тяжелых инфекций.
- Легкие. Симптоматически поражение легких аналогично монофокальному гистиоцитозу.
- Эндокринные железы. Нарушение работы эндокринных желез в основном связано с поражением гипофиза — железы, которая регулирует всю работу эндокринной системы. Проявляется это не только несахарным диабетом, но и нарушением работы щитовидной железы, надпочечников и др.
- Центральная нервная система. Симптомы будут зависеть от локализации патологических очагов. Это может быть, как общемозговая симптоматика (нарушение сознания, судороги), так и очаговые неврологические проявления.
- Желудочно-кишечный тракт. Для гистиоцитоза характерны симптомы энтероколита (тошнота, рвота, диарея, боль в животе.
Диагностика гистиоцитоза
Решающим методом диагностики гистиоцитоза является гистологическое исследование биопсийного материала из патологических очагов с проведением иммуногистохимии. Патогномическим признаком является экспрессия клетками CD1a и S100, также широкий интерес представляет определение CD207.
Кроме того, все больные гистиоцитозом должны проходить комплексное обследование для определения формы заболевания и оценки текущего состояния. Назначаются лабораторные анализы, проводится УЗИ внутренних органов, выполняется рентгенография костей. При необходимости, пациент получает консультацию узких специалистов.
Лечение гистиоцитоза
Лечение гистиоцитоза зависит от клинических проявлений заболевания. При поражении кожи назначаются следующие средства:
- Топические глюкокортикостероиды.
- PUVA-терапия.
- Хирургическое иссечение единичных новообразований.
- Лучевая терапия.
- Винбластин.
При поражении костей назначают следующее лечение:
- Кюретаж патологических очагов.
- Лучевая терапия в низких дозах.
- Назначение винбластина и бисфосфонатов.
При лечении мультифокальных и диссеминированных форм применяется полихимиотерапия, терапия 2-хлородеоксиаденозином, а также терапия аллогенными стволовыми клетками. Неплохие результаты показало лечение талидомидом и алемтизумабом, но эти препараты пока находятся в фазе клинических испытаний. При лечении резистентных форм гистиоцитоза применяют кладрибин.
Прогноз при гистиоцитозе
Прогноз при гистиоцитозе будет зависеть от вида заболевания. Локализованные формы в основном протекают доброкачественно и склонны к спонтанным ремиссиям. Диссеминированные формы гистиоцитоза могут быстро прогрессировать и приводить к летальному исходу. Прогностическим индикатором является реакция на полихимиотерапию. При хорошей реакции опухоли общая выживаемость составляет 89-91%, а при первичной резистентности она снижается до 17-34%.
В клинике «Евроонко» для лечения гистиоцитоза используются новейшие лекарственные препараты согласно современным стандартам, а в сложных случаях решение принимается коллегиально консилиумом специалистов.
Гистиоцитоз X ( Гистиоцитоз из клеток Лангерганса , Легочная эозинофильная гранулема )
Гистиоцитоз Х – это системное заболевание, характеризующееся образованием специфических клеточных гранулем в различных органах и тканях. Наиболее типичные клинические проявления включают кожные высыпания, кашель, односторонний экзофтальм. Также наблюдаются выпадение зубов, увеличение периферических лимфатических узлов, признаки несахарного диабета (полиурия, полидипсия). Диагноз верифицируется путем гистологического исследования кожи, легких или лимфатических узлов. В качестве лечения применяются противовоспалительные препараты (глюкокортикостероиды), химиотерапевтические средства. В случае выраженного поражения легких производится трансплантация органа.
МКБ-10
![Гистиоцитоз X]()
![Гистиоцитоз из клеток Лангерганса]()
![Рентгенография легких. Диффузные двусторонние узловые затемнения и небольшие кисты в верхней и средней доле]()
Общие сведения
Гистиоцитоз Х (гистиоцитоз из клеток Лангерганса, легочная эозинофильная гранулема) – системная патология, при которой происходит активная пролиферация клеток Лангерганса в тканях легких, костей, центральной нервной системы, ретикуло-эндотелиальной системы (в печени, селезенке, лимфатических узлах). Течение заболевания варьирует в зависимости от формы и может быть доброкачественным со спонтанной ремиссией или быстропрогрессирующим с высокой вероятностью летального исхода. Распространенность гистиоцитоза составляет 5 на 1 000 000 человек. Преимущественно страдают дети, подростки, взрослые в возрасте 20-30 лет. Гистиоцитоз встречается только у представителей белой расы, чаще у мужчин (соотношение с женщинами 2:1).
![Гистиоцитоз X]()
Причины
На сегодняшний день точная причина гистиоцитоза неизвестна. Предполагается роль иммунной аутоагрессии, вызванной инфицированием вируса герпеса 6-го типа. До сих пор ведутся научные дебаты о наследственной природе заболевания. У 50% пациентов в патологических клетках Лангерганса была обнаружена соматическая мутация гена V600E, кодирующего внутриклеточный сигнальный белок BRAF. Табакокурение рассматривается как один из основных факторов риска (более 90% больных являются курильщиками). Подтверждением этого служит тот факт, что симптоматика уменьшается после прекращения курения даже без применения какого-либо лечения.
Патогенез
Механизм развития гистиоцитоза изучен недостаточно. Основным звеном патогенеза считается накопление в тканях дендритных клеток (клеток Лангерганса, или гистиоцитов). Дендритные клетки синтезируются в костном мозге и мигрируют в дерму, паренхиму легких, ретикулоэндотелиальную систему и т.д. Их основная функция заключается в поглощении антигенов, поступающих из окружающей среды, и презентации Т и В-лимфоцитам для формирования иммунного ответа. После контакта с гистиоцитами лимфоциты начинают выделять провоспалительные цитокины и медиаторы, повышающие активность гистиоцитов и придающие им высокую подвижность.
При гистиоцитозе по неизвестным причинам у дендритных клеток нарушается процесс апоптоза (запрограммированной клеточной гибели). В сочетании с выделяемыми лимфоцитами факторами роста это приводит к их интенсивной пролиферации с последующим слиянием с эозинофилами. В результате образуются гигантоклеточные гранулемы, которые постепенно начинают замещать нормально функционирующую ткань того или иного органа. Присутствие большого количества Т-лимфоцитов в гранулемах позволяет предположить наличие специфического антигена.
Классификация
По локализации очагов выделяют моносистемную форму с единичным или множественным поражением одной анатомической области и мультисистемную форму с признаками нарушения функции органов или без них. Традиционно различают следующие клинические формы:
- Диссеминированная (первично-острая, болезнь Абта—Леттерера—Сиве). Течение напоминает тяжелую системную инфекцию. Характеризуется быстрой генерализацией процесса, прогрессированием легочной недостаточности и высокой частотой летальности. Чаще возникает у детей от 6 месяцев до 2 лет.
- Первично-хроническая (болезнь Хенда—Шюллера—Крисчена). Течение также системное, но более благоприятное, различные органы вовлекаются постепенно. Типична триада Крисчена – несахарный диабет, односторонний экзофтальм и деструкция плоских костей черепа. Встречается у детей и подростков.
- Эозинофильная гранулема(болезнь Таратынова). Наиболее доброкачественный вид. Преимущественная локализация гранулем - кости и легкие. В большинстве случаев развивается у взрослых.
![Гистиоцитоз из клеток Лангерганса]()
Симптомы гистиоцитоза
Клиническая картина крайне разнообразна. Заболевание начинается с появления общей слабости, повышения температуры тела, которая в основном бывает субфебрильной, но может достигать 40°С. Возможны диспепсические нарушения – тошнота, рвота, диарея. Кожа покрывается зудящими очагами гиперемии с чешуйками или корочками. Иногда наблюдаются геморрагические элементы, длительно незаживающие язвы. Высыпания присутствуют на коже головы, наружного слухового прохода, в области естественных складок (паховой, подмышечной). Увеличиваются лимфатические узлы по всему телу.
Возникает одышка, упорный сухой кашель и боли в грудной клетке. Затруднение дыхания может беспокоить только во время физической нагрузки или присутствовать даже в покое. Присоединяются тупые боли или тяжесть в правом подреберье из-за увеличения печени (гепатомегалии). При выраженном поражении печени кожа приобретает желтушный оттенок. Увеличение селезенки сопровождается болью в левом подреберье. Некоторые пациенты испытывают боль в костях. Деструкция костей глазницы ведет к образованию экзофтальма, чаще одностороннего. Боль в ухе ошибочно диагностируется как бактериальный или грибковый отит и безуспешно лечится антибактериальными и противогрибковыми препаратами. Остеолизис нижней челюсти приводит к периодонтитам и выпадению зубов.
При длительном течении гистиоцитоза больной начинает терять вес. В тяжелых случаях встречаются признаки костномозговой недостаточности – анемический синдром (бледность кожи, головокружение, учащенное сердцебиение), склонность к кровотечениям, сниженная сопротивляемость к инфекциям. Формирование гистиоцитарных гранулем в задней доле гипофиза вызывает угнетение выработки антидиуретического гормона. В результате развивается симптоматика несахарного диабета – сухость во рту, постоянная жажда (полидипсия) и повышенное мочеотделение (полиурия).
Осложнения
Широкая вариативность клинической картины при гистиоцитозе обусловливает разнообразие осложнений. Наиболее характерными считаются патологические переломы костей, особенно компрессионный перелом позвоночника. Типичные осложнения со стороны легких – легочная артериальная гипертензия вследствие диффузного фиброза легочной ткани, спонтанный пневмоторакс из-за разрыва тонкостенных булл. Массивная инфильтрация печени вызывает цирроз с печеночно-клеточной недостаточностью. К редким осложнениям относятся неблагоприятные последствия дефицита антидиуретического гормона (несахарного диабета) в виде гиперосмолярной гипогидратации, проявляющейся двигательным беспокойством, мышечными судорогами, нарушением сознания, вплоть до глубокой комы.
Диагностика
Пациентами с гистиоцитозом занимаются различные врачи – гематологи, пульмонологи, педиатры. Профиль специальности зависит от возраста больного и преимущественно пораженного органа. При общем осмотре отмечаются цианоз (синюшность) губ, участие в дыхании вспомогательной мускулатуры (при дыхательной недостаточности). При аускультации легких выслушивается жесткое дыхание, сухие хрипы по всем легочным полям. Дополнительное обследование включает:
- Лабораторные тесты. В общем анализе крови обнаруживаются ускорение скорости оседания эритроцитов, иногда эозинофилия и панцитопения (уменьшение эритроцитов, тромбоцитов и лейкоцитов). В биохимии крови может прослеживаться увеличение печеночных ферментов (АЛТ, АСТ) и повышение осмолярности плазмы. При печеночной недостаточности изменяются показатели коагулограммы (удлинение протромбинового времени, гипофибриногенемия). В анализе мочи наблюдается низкая относительная плотность (гипостенурия).
- Инструментальные исследования. При рентгенографии скелета находят очаги деструкции и остеолизиса, особенно выраженные в плоских костях черепа и длинных трубчатых костях. На рентгенограмме органов грудной клетки видны двусторонние мелкоочаговые затемнения (узелки, буллы), усиление легочного рисунка. Для более точной визуализации легочной ткани назначается компьютерная томография легких высокого разрешения, позволяющая определить их ячеистую деформацию. Результаты измерения функции внешнего дыхания (спирографии) показывают ухудшение диффузионной емкости легких.
- Верифицирующие тесты. Позволяют достоверно установить диагноз гистиоцитоза. При гистологическом исследовании биоптата (чаще кожи, лимфатических узлов или легких) выявляется избыточное количество гигантских клеток Лангерганса с эозинофильной цитоплазмой, бобовидной формой ядра, отсутствием ядрышек. Для идентификации поверхностных специфических маркеров гистиоцитоза (CD 1а и лангерина) проводится иммуногистохимический анализ.
Дифференциальный ряд включает большое количество нозологий и зависит от клинических симптомов гистиоцитоза. Кожные высыпания нужно дифференцировать с экземой, псориазом, атопическим дерматитом. Поражение легких следует отличать от туберкулеза, саркоидоза, лимфогранулематоза. Генерализованный гистиоцитоз дифференцируют с гематологическими заболеваниями (гемофагоцитарный синдром, острый лейкоз). Очаги деструкции костей требуют исключения гиперпаратиреоза, множественной миеломы, остеомиелита.
![Рентгенография легких. Диффузные двусторонние узловые затемнения и небольшие кисты в верхней и средней доле]()
Рентгенография легких. Диффузные двусторонние узловые затемнения и небольшие кисты в верхней и средней доле
Лечение гистиоцитоза
Пациенты обязательно должны быть госпитализированы в стационар. При тяжелой дыхательной недостаточности показаны ингаляции кислорода или перевод на искусственную вентиляцию легких. При наличии признаков костномозговой недостаточности прибегают к переливанию компонентов крови и применению гранулоцитарного колониестимулирующего фактора.
Этиотропной терапии гистиоцитоза Х не существует. Наиболее важный этап в лечении – отказ от курения. Прекращение курения вызывает улучшение клинической, лабораторной, рентгенологической картины. В качестве патогенетической терапии используют глюкокортикостероиды (преднизолон, метилпреднизолон), химиотерапевтические средства (винбластин, меркаптопурин, этопозид).
Для лечения несахарного диабета назначается заместительная гормональная терапия аналогами вазопрессина (десмопрессин) в виде интраназального спрея или в таблетированной форме. При небольших остеолитических очагах выполняют кюретаж, при выраженной инфильтрации костей – резекцию или дистанционную гамма-терапию. При массивном деструктивном процессе в легочной ткани проводится трансплантация легких.
Прогноз и профилактика
Течение и прогноз при гистиоцитозе Х определяется формой заболевания. Первично-острая форма характеризуется быстропрогрессирующим течением с неблагоприятным прогнозом. Смерть наступает в 70-80% случаев от легочно-сердечной недостаточности. Первично-хроническая форма и эозинофильная гранулема имеют более доброкачественное течение. Риск летальности составляет 15% и 1,5% соответственно. Иногда происходит спонтанное выздоровление. Так как причина развития гистиоцитоза неизвестна, эффективных методов профилактики не разработано. Уменьшить риск возникновения и рецидива может отказ от табакокурения.
1. Доброкачественное течение гистиоцитоза Х/ Шихнебиев Д.А., Эседов Э.М., Джалилова Л.М.// Клиническая медицина. – 2002 - №7.
2. Роль дерматолога в диагностике гистиоцитоза из клеток Лангерганса/ Мошкалова И.А.// Учебные записки СПбГМУ им. акад. И.П. Павлова. - 2001, т. VIII, №4.
4. Легочный гистиоцитоз Х — современные представления, диагностика и тактика лечения/ Корнев Б.М., Коган Е.А., Попов Е.Н. и др.// Терапевтический архив - 2003 - №5.
Читайте также: